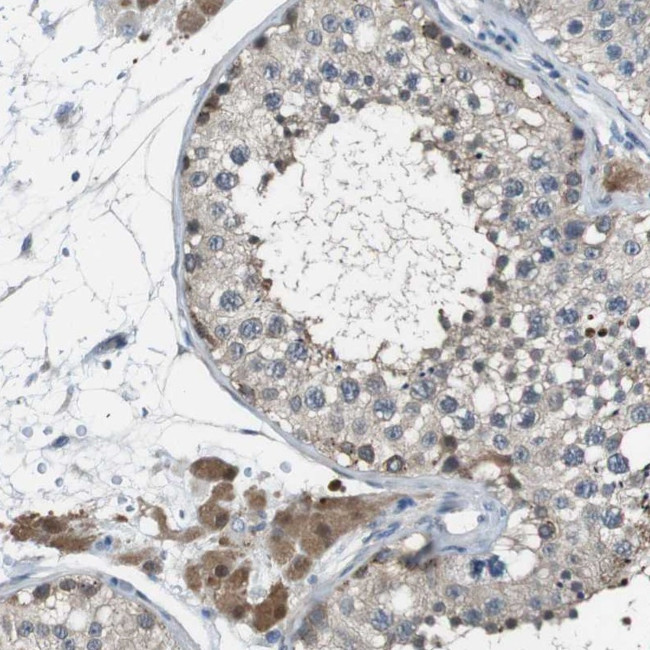
NANOS2 Antibody in Immunohistochemistry (Paraffin) (IHC (P))

Search
Invitrogen
NANOS2 Polyclonal Antibody
{{$productOrderCtrl.translations['antibody.pdp.commerceCard.promotion.promotions']}}
{{$productOrderCtrl.translations['antibody.pdp.commerceCard.promotion.viewpromo']}}
{{$productOrderCtrl.translations['antibody.pdp.commerceCard.promotion.promocode']}}: {{promo.promoCode}} {{promo.promoTitle}} {{promo.promoDescription}}. {{$productOrderCtrl.translations['antibody.pdp.commerceCard.promotion.learnmore']}}
产品信息
PA5-53131
种属反应
宿主/亚型
分类
类型
抗原
偶联物
形式
浓度
规格
纯化类型
保存液
内含物
保存条件
运输条件
RRID
产品详细信息
Immunogen sequence: MQLPPFDMWK DYFNLSQVVW ALIASRGQRL ETQEIEEPSP GPPLGQDQGL GAPGANGGLG TLCNFCKHNG ESRHVYSSHQ LKTPDGVVVC PILRHYVCPV CGATGDQAHT LKYCPLNGGQ QSLYRRSGRN SAGRRVKR
Highest antigen sequence identity to the following orthologs: Mouse - 75%, Rat - 74%.
靶标信息
NANOS2 is a gene that encodes for a protein found in the testes and ovaries. It is a member of the NANOS family of proteins and plays a crucial role in the regulation of germ cell development. NANOS2 is involved in the maintenance of germ cell pluripotency and the suppression of somatic cell differentiation. It is also involved in the regulation of meiosis and the formation of gametes. Mutations in the NANOS2 gene have been associated with various reproductive disorders, including infertility and testicular germ cell tumors. NANOS2 is a target of research in the fields of reproductive biology and genetics.
仅用于科研。不用于诊断过程。未经明确授权不得转售。
篇参考文献 (0)
生物信息学
蛋白别名: Nanos homolog 2; NOS-2
基因别名: NANOS2; NOS2; ZC2HC12B
UniProt ID: (Human) P60321
Entrez Gene ID: (Human) 339345